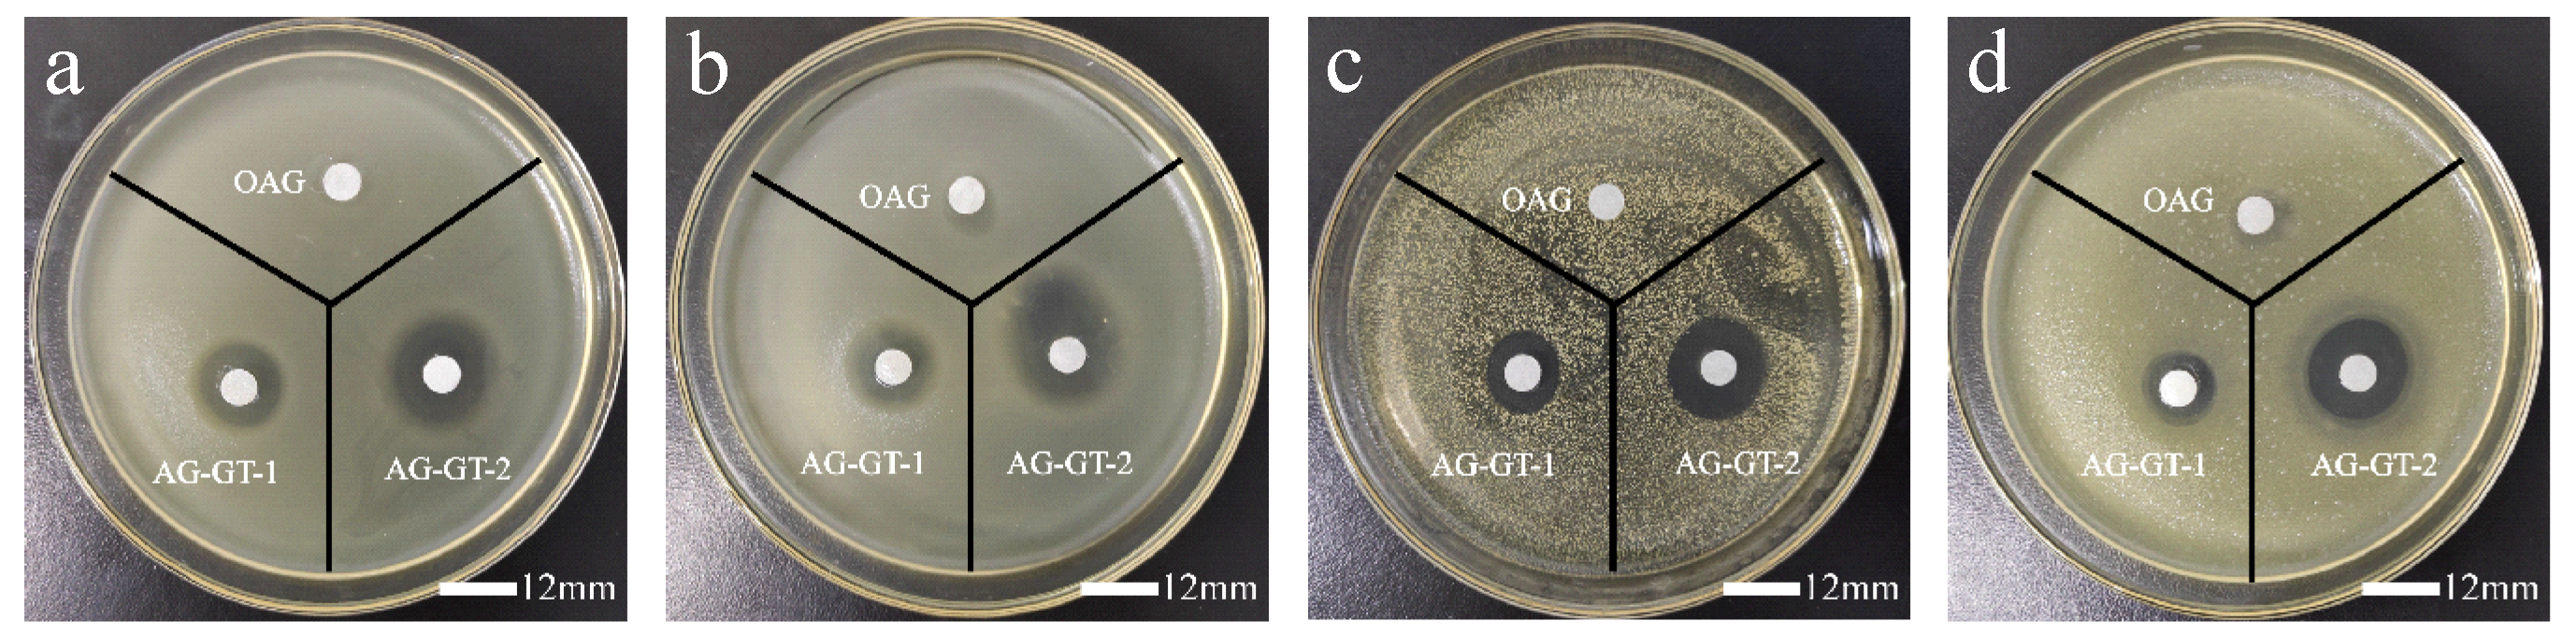
Polymers 14 02975 g003

Synthesis of Gentamicin-Immobilized Agar with Improved Antibacterial Activity
Abstract
:1. Introduction
2. Materials and Methods
2.1. Materials
2.2. AG-GT Synthesis
2.3. Characterization
2.4. Gelling and Melting Temperatures
2.5. Antibacterial Assays
3. Results and Discussion
3.1. Characterization
3.1.1. Chemical Structure
3.1.2. Gelling and Melting Temperatures
3.2. Inhibition Zone
3.3. MIC and MBC
3.4. Biofilm Inhibition
4. Conclusions
Author Contributions
Funding
Institutional Review Board Statement
Informed Consent Statement
Data Availability Statement
Conflicts of Interest
References
- Wang, L.J.; Shen, Z.P.; Mu, H.M.; Lin, Y.; Zhang, J.L.; Jiang, X.L. Impact of alkali pretreatment on yield, physico-chemical and gelling properties of high quality agar from Gracilaria tenuistipitata. Food Hydrocoll. 2017, 70, 356–362. [Google Scholar] [CrossRef]
- Chen, H.J.; Xiao, Q.; Weng, H.F.; Zhang, Y.H.; Yang, Q.M.; Xiao, A.F. Extraction of sulfated agar from Gracilaria lemaneiformis using hydrogen peroxide-assisted enzymatic method. Carbohydr. Polym. 2020, 232, 115790. [Google Scholar] [CrossRef] [PubMed]
- Zhang, X.D.; Liu, X.; Xia, K.; Luan, J.M. Preparation of oxidized agar and characterization of its properties. Carbohydr. Polym. 2014, 112, 583–586. [Google Scholar] [CrossRef] [PubMed]
- Yarnpakdee, S.; Benjakul, S.; Kingwascharapong, P. Physico-chemical and gel properties of agar from Gracilaria tenuistipitata from the lake of Songkhla, Thailand. Food Hydrocoll. 2015, 51, 217–226. [Google Scholar] [CrossRef]
- Zhang, N.; Wang, J.; Ye, J.; Zhao, P.; Xiao, M. Oxyalkylation modification as a promising method for preparing low-melting-point agarose. Int. J. Biol. Macromol. 2018, 117, 696–703. [Google Scholar] [CrossRef]
- Gu, Y.; Cheong, K.L.; Du, H. Modification and comparison of three Gracilaria spp. agarose with methylation for promotion of its gelling properties. Chem. Cent. J. 2017, 11, 104. [Google Scholar] [CrossRef] [PubMed] [Green Version]
- Chen, H.; Chen, F.; Xiao, Q.; Cai, M.; Yang, Q.; Weng, H.; Xiao, A. Structure and physicochemical properties of amphiphilic agar modified with octenyl succinic anhydride. Carbohydr. Polym. 2021, 251, 117031. [Google Scholar] [CrossRef] [PubMed]
- Sivashankari, P.R.; Prabaharan, M. Three-dimensional porous scaffolds based on agarose/chitosan/graphene oxide composite for tissue engineering. Int. J. Biol. Macromol. 2020, 146, 222–231. [Google Scholar] [CrossRef] [PubMed]
- Ghasemzadeh, H.; Afraz, S.; Moradi, M.; Hassanpour, S. Antimicrobial chitosan-agarose full polysaccharide silver nanocomposite films. Int. J. Biol. Macromol. 2021, 179, 532–541. [Google Scholar] [CrossRef] [PubMed]
- Forget, A.; Arya, N.; Ranndriantsilefisoa, R.; Miessmer, F.; Buc, M.; Ahmadi, V.; Jona, D.; Blencowe, A.; Shastri, V.P. Nonwoven Carboxylated Agarose-Based Fiber Meshes with Antimicrobial Properties. Biomacromolecules 2016, 17, 4021–4026. [Google Scholar] [CrossRef] [PubMed]
- Zhang, Z.; Wang, X.; Wang, Y.; Hao, J. Rapid-Forming and Self-Healing Agarose-Based Hydrogels for Tissue Adhesives and Potential Wound Dressings. Biomacromolecules 2018, 19, 980–988. [Google Scholar] [CrossRef] [PubMed]
- Rivadeneira, J.; Audisio, M.C.; Gorustovich, A. Films based on soy protein-agar blends for wound dressing: Effect of different biopolymer proportions on the drug release rate and the physical and antibacterial properties of the films. J. Biomater. Appl. 2018, 32, 1231–1238. [Google Scholar] [CrossRef] [PubMed]
- Polat, T.G.; Duman, O.; Tunc, S. Agar/kappa-carrageenan/montmorillonite nanocomposite hydrogels for wound dressing applications. Int. J. Biol. Macromol. 2020, 164, 4591–4602. [Google Scholar] [CrossRef] [PubMed]
- Heuko, J.G.; Duarte, M.E.R.; Gonçalves, A.G.; Noseda, M.D.; Murakami, F.S.; de Carvalho, M.M.; Ducatti, D.R. Synthesis of C6-amino agarose and evaluation of its antibacterial activity. Carbohydr. Res. 2021, 507, 108387. [Google Scholar] [CrossRef] [PubMed]
- Liang, F.; Li, C.; Hou, T.; Wen, C.; Kong, S.; Ma, D.; Sun, C.; Li, S. Effects of Chitosan-Gentamicin Conjugate Supplement on Non-Specific Immunity, Aquaculture Water, Intestinal Histology and Microbiota of Pacific White Shrimp (Litopenaeus vannamei). Mar. Drugs 2020, 18, 419. [Google Scholar] [CrossRef] [PubMed]
- Liang, F.; Sun, C.; Li, S.; Hou, T.; Li, C. Therapeutic effect and immune mechanism of chitosan-gentamicin conjugate on Pacific white shrimp (Litopenaeus vannamei) infected with Vibrio parahaemolyticus. Carbohydr. Polym. 2021, 269, 118334. [Google Scholar] [CrossRef] [PubMed]
- Yan, T.; Li, C.; Ouyang, Q.; Zhang, D.; Zhong, Q.; Li, P.; Li, S.; Yang, Z.; Wang, T.; Zhao, Q. Synthesis of gentamicin-grafted-chitosan with improved solubility and antibacterial activity. React. Funct. Polym. 2019, 137, 38–45. [Google Scholar] [CrossRef]
- Zhang, X.D.; Liu, X.L.; Cao, M.Z.; Xia, K.; Zhang, Y.Q. Preparation of hydroxypropyl agars and their properties. Carbohydr. Polym. 2015, 129, 87–91. [Google Scholar] [PubMed]

| Samples | C (%) | N (%) | O (%) |
|---|---|---|---|
| AG | 38.24 | 0.16 | 56.38 |
| OAG | 29.65 | 0.20 | 64.24 |
| AG-GT-1 | 37.33 | 1.35 | 55.23 |
| AG-GT-2 | 36.84 | 1.86 | 54.17 |
| Samples | Concentrations (mg mL−1) | E. coli (mm) | S. aureus (mm) |
|---|---|---|---|
| GT | 5 | 23.75 ± 0.93 | 23.01 ± 0.97 |
| 10 | 25.75 ± 0.66 | 24.27 ± 0.55 | |
| OAG | 5 | 7.12 ± 0.49 | - |
| 10 | 8.58 ± 0.53 | 8.3 ± 1.37 | |
| AG-GT-1 | 5 | 14.32 ± 0.70 | 14.23 ± 0.28 |
| 10 | 15.83 ± 0.94 | 15.55 ± 0.47 | |
| AG-GT-2 | 5 | 18.98 ± 0.80 | 17.98 ± 0.36 |
| 10 | 20.26 ± 0.34 | 19.32 ± 0.87 |
| Samples | E. coli | S. aureus | ||
|---|---|---|---|---|
| MIC (μg/mL) | MBC (μg/mL) | MIC (μg/mL) | MBC (μg/mL) | |
| GT | 7.81 | 15.63 | 3.91 | 7.81 |
| AG-GT-1 | 156.2 | 625 | 78.1 | 312.5 |
| AG-GT-2 | 39.1 | 156.2 | 19.5 | 78.1 |
Publisher’s Note: MDPI stays neutral with regard to jurisdictional claims in published maps and institutional affiliations. |
© 2022 by the authors. Licensee MDPI, Basel, Switzerland. This article is an open access article distributed under the terms and conditions of the Creative Commons Attribution (CC BY) license (https://creativecommons.org/licenses/by/4.0/).
Share and Cite
Hou, T.; Wen, X.; Xie, L.; Gu, Q.; Li, C. Synthesis of Gentamicin-Immobilized Agar with Improved Antibacterial Activity. Polymers 2022, 14, 2975. https://doi.org/10.3390/polym14152975
Hou T, Wen X, Xie L, Gu Q, Li C. Synthesis of Gentamicin-Immobilized Agar with Improved Antibacterial Activity. Polymers. 2022; 14(15):2975. https://doi.org/10.3390/polym14152975
Chicago/Turabian StyleHou, Tingting, Xin Wen, Lici Xie, Qixiang Gu, and Chengpeng Li. 2022. "Synthesis of Gentamicin-Immobilized Agar with Improved Antibacterial Activity" Polymers 14, no. 15: 2975. https://doi.org/10.3390/polym14152975
APA StyleHou, T., Wen, X., Xie, L., Gu, Q., & Li, C. (2022). Synthesis of Gentamicin-Immobilized Agar with Improved Antibacterial Activity. Polymers, 14(15), 2975. https://doi.org/10.3390/polym14152975
